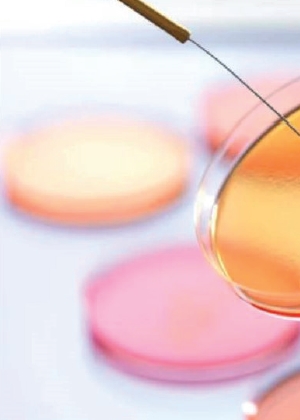

En un mundo donde la sostenibilidad es clave, e iniciativas como el uso de ingredientes upcycled o materiales reciclados se han vuelto indispensables en la industria cosmética, no podemos perder de vista, sin embargo, otros aspectos cruciales del proceso de producción como el control de calidad.
Desde el diseño hasta la seguridad del envase en manos del consumidor final, este departamento vela por la integridad de los productos cosméticos, asegurando su compatibilidad y confiabilidad.
La industria cosmética es un sector en constante evolución, donde la innovación y la sostenibilidad se entrelazan con la creciente demanda de los consumidores en busca de productos de belleza de la más alta calidad. Este fenómeno no se limita únicamente a la formulación de los productos en sí, sino que también se extiende al diseño de los envases que los contienen. En este sentido, la Comisión Europea, en concreto, está impulsando medidas legislativas destinadas a promover la reutilización de envases, lo que está motivando al sector del envase a enfocarse en la fabricación de envases reutilizables. Si bien esta práctica es adecuada cuando se lleva a cabo de manera higiénica y controlada en los puntos de venta a través de sistemas cerrados, es importante señalar que su ejecución incorrecta o la utilización de envases inapropiados pueden tener repercusiones negativas en la calidad microbiológica y la seguridad de los productos cosméticos.
Calidad microbiológica: Un punto crítico
Uno de los desafíos más significativos vinculados a la reutilización de envases en la industria cosmética está relacionado con la calidad microbiológica. Los productos cosméticos, están formulados con un enfoque prioritario en la garantía de la seguridad de los consumidores a lo largo de toda la vida útil del producto. Esto implica que cada producto cosmético debe cumplir con rigurosos estándares de calidad microbiológica. Para cumplir con este objetivo, desde las etapas iniciales de diseño, se consideran tanto la formulación del producto como el tipo de envase en el que va a ser contenido.
Cuando los consumidores optan por reutilizar envases o transfieren los productos a recipientes distintos a los originales se incrementa de manera significativa el riesgo de contaminación. Esto se debe a que los envases secundarios pueden contener residuos de otros productos o no haber sido debidamente higienizados. Esto implica que el proceso de trasvasar los productos podría no cumplir con las condiciones adecuadas, lo que potencialmente podría dar lugar a la proliferación de bacterias, hongos y levaduras en los productos cosméticos. Esta situación, a su vez, puede derivar en consecuencias negativas para la salud, incluyendo irritaciones, infecciones cutáneas y otros problemas dermatológicos.
Es importante destacar que este riesgo no se limita exclusivamente al envase principal del producto, sino que también se extiende a los accesorios de aplicación, como bombas, aerosoles y pinceles. Cualquier accesorio que no se mantenga en condiciones óptimas de higiene corre el riesgo de encontrarse contaminado, lo que puede representar una amenaza adicional para la integridad microbiológica de los productos cosméticos y, en última instancia, para la salud de quienes los utilizan.
Seguridad y composición: Un desafío latente
Otro aspecto crítico que merece atención es la estabilidad de los activos y excipientes presentes en la fórmula. Cada producto cosmético se formula de manera minuciosa con el propósito de asegurar que sus ingredientes se mantengan estables y seguros a lo largo de toda su vida útil, considerando, entre otras cosas, el envase en el que serán almacenados. Sin embargo, cuando se lleva a cabo la transferencia de estos productos a envases inapropiados, surge el riesgo inminente de que se produzcan alteraciones en la composición de dichos productos.
Un envase inadecuado puede no proporcionar un sellado hermético, lo que abre la puerta a la entrada de oxígeno y la exposición a la luz. Esta exposición, a su vez, puede provocar la degradación del producto cosmético, lo que conlleva la pérdida de eficacia y la posibilidad de comprometer la seguridad del usuario.
Adicionalmente, es fundamental destacar la ausencia de ensayos y pruebas que demuestren la compatibilidad entre el envase y el producto cosmético. Esta carencia representa un riesgo significativo para la seguridad del consumidor, ya que el producto puede interactuar con el envase, lo que podría resultar en la liberación de sustancias químicas reguladas, como ciertos plastificantes, que potencialmente superarían los límites de seguridad establecidos por la Comisión Europea. Este escenario, sin lugar a dudas, podría tener consecuencias perjudiciales para la salud del usuario y socavar la integridad misma del producto cosmético.

Recomendaciones para un uso seguro de cosméticos
Para abordar con responsabilidad los desafíos asociados a la reutilización de envases y el trasvase de productos cosméticos, es crucial que los consumidores sigan estas recomendaciones:
- Evitar la reutilización de envases cosméticos: Resistir la tentación de rellenar envases vacíos con otros productos. Esta práctica conlleva un mayor riesgo de contaminación y alteración de la composición, lo que puede afectar negativamente la calidad y seguridad del producto. Sobre todo para aquellos productos que se aplican en zonas de mucosas, zona ocular, productos de tratamiento y cuidado infantil.
- Mantener los envases originales: En la medida de lo posible, conservar los productos cosméticos en sus envases originales. Estos envases han sido sometidos a rigurosas evaluaciones de calidad para garantizar la estabilidad, compatibilidad y seguridad del producto a lo largo de su vida útil.
- Verificar la fecha de caducidad o PAO (Período de Apertura): Los productos cosméticos se someten a pruebas exhaustivas de estabilidad, lo que permite determinar el período de vida útil del producto. Respetar la fecha de caducidad o el PAO asegura que el cosmético mantenga su eficacia y seguridad durante el tiempo especificado.
En resumen, la reutilización de envases o accesorios y la transferencia de productos a envases inadecuados o que no presentan una higienización óptima plantean desafíos significativos en términos de calidad microbiológica y seguridad en la industria cosmética. Los consumidores deben ser conscientes de estos riesgos y tomar medidas para garantizar un uso seguro y eficaz de sus productos de belleza. En este sentido, la industria tiene la responsabilidad de aconsejar a los consumidores sobre estos temas, aunque priorizar la seguridad del usuario pueda contradecir la promoción de prácticas más sostenibles.
Descarga sugerida:
Artículo escrito por:
Laura Rubio
Responsable del Dpto. de Estabilidad
,Dr. Goya Análisis (Grupo Virtus)